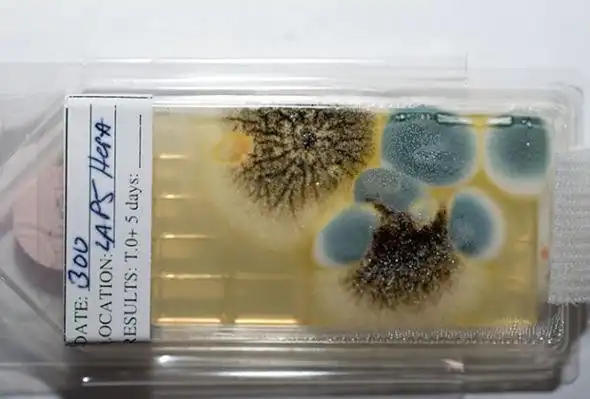

Космическая зараза
Кадр из фильма «Штамм Андромеда»
Недавнее открытие экзопланеты Kepler-452b, по своим характеристикам очень близкой к Земле, вновь подстегнуло интерес к возможной встрече с инопланетной жизнью. Однако эта проблема уже давно переведена в практическую плоскость: еще на заре космической эры СССР и США разработали единую систему защиты Земли от инопланетных микроорганизмов — и наоборот.
Каковы плюсы и минусы этой системы? И дают ли последние открытия астробиологов и планетологов основания для ослабления правил жесткого карантина? Сейчас мы попробуем в этом разобраться …
Нельзя пускать чужую жизнь на нашу планету — и точно так же нельзя заражать чужие планеты своей жизнью, если там есть хотя бы подозрение на собственную. Эта мантра, пусть немножко в других словах, прозвучала на Земле почти в самом начале эры освоения космического пространства. В 1967 году в самый разгар холодной войны СССР и США, в то время единственные страны, способные на такое освоение, заключили между собой Договор о космосе («Договор о принципах деятельности государств по исследованию и использованию космического пространства, включая Луну и другие небесные тела»), где, в частности, впервые провозглашался принцип незаражения.
Глава IX гласит: «Государства — участники Договора осуществляют изучение и исследование космического пространства, включая Луну и другие небесные тела, таким образом, чтобы избегать их вредного загрязнения, а также неблагоприятных изменений земной среды вследствие доставки внеземного вещества, и с этой целью, в случае необходимости, принимают соответствующие меры».
Любопытно, что с тех пор и по сию пору ничего подобного этим консультациям между участниками быстро расширяющегося клуба космических государств ни разу не проводилось — во всяком случае, публике об этом ничего не известно. Осмелимся предположить, что уж в чем, в чем, а в этом каждая космическая страна была с участниками договора полностью солидарна.
Что делать
Беда в том, что вот уже полвека прошло со времени подписания этого договора, а ученые так до сих пор и не пришли к соглашению, каким образом его следует соблюдать. Понятно, что если мы вдруг наткнемся на зеленых человечков, да еще и оснащенных оружием, мы постараемся держаться от них подальше, разве что обменяемся посольствами, надежно заблокированными от чуждого воздействия и, скорее всего, размещенными на ближайших спутниках, лишенных всякого подобия жизни. Однако речь в первую очередь идет не об этой научной фантастике, а о защите земных микроорганизмов от инопланетных и наоборот. Поэтому загрязнение, о котором идет речь в Договоре о космосе, делится учеными на две категории — прямое загрязнение чужой микрожизни нашими микробами (forward contamination) и обратное (back contamination), при котором возможно заражение биосферы Земли инопланетными организмами.
Астронавт Нил Армстронг посылает воздушный поцелуй
своим сыновьям из карантина в Хьюстоне после возвращения
с Луны, 27 июля 1969 года
своим сыновьям из карантина в Хьюстоне после возвращения
с Луны, 27 июля 1969 года
Возможно также, что если и есть опасность загрязнения, то она невелика, — даже если чужой микроб, чужая спора или бактерия попадет в земные условия, то среди мириад незнакомых ему микроорганизмов, против которых у него нет защиты, чужак с высокой степенью вероятности погибнет, как это случилось с воинственными марсианскими пришельцами в «Войне миров» Герберта Уэллса. Однако если все-таки выживет и начнет размножаться, ситуация перевернется, и уже он станет представлять фатальную угрозу жизни на нашей планете. То же самое справедливо и для земных микроорганизмов, попадающих на другие планеты, где предположительно может существовать своя собственная жизнь, и, стало быть, принцип «не зарази», при всей маловероятности одноклеточных апокалипсисов, должен неукоснительно соблюдаться.
Обратное загрязнение
В первую очередь людей волнует обратное загрязнение: важно понять, как избежать смертельно опасного вторжения извне. Поскольку инопланетных микроорганизмов до сих пор не найдено, ученые работают с земными малютками — экстремофилами, которые способны жить и размножаться в экстремальных условиях — при очень высоких температурах, при космическом холоде, при чрезмерных давлениях, высокой радиации. Неизвестно, способны ли существующие у нас экстремофилы уничтожить биоту целой планеты, к их атаке не подготовленную, но то, что эти теоретические убийцы обязаны быть экстремофилами, сомнению не подлежит. И таких экстремофилов, оказывается, вполне хватает и на Земле.
Штаммы микроорганизмов с Международной космической станции
Проблема защиты от обратного заражения из теоретической перешла в практическую плоскость еще в 60-х годах, при посещении Луны американскими астронавтами и их возвращении с образцами лунного грунта. В то время ученые не знали, есть ли на Луне жизнь (разумеется, в виде бактерий, а не зеленых человечков), и защита от предполагаемых лунных жителей была очень громоздкой и серьезной, хотя основной ее принцип был прост: «уходя, вымыть руки и вытереть ноги». Находясь на Луне, космонавты старались не занести с собой пыль внутрь возвращаемого модуля и не позволить ей осесть на поверхности корабля. Возвратившись, участники лунной экспедиции три недели находились на карантине, а образцы изучались в специальной лаборатории Хьюстона с соблюдением всех мер предосторожности, пока не было доказано, что никаких лунных микроорганизмов они не содержат.
Методы защиты от обратного загрязнения при возможной доставке на Землю образцов грунта с Марса, разработанные в НАСА, еще серьезнее. Здесь будет работать принцип «разорвать цепь контакта», при котором любое оборудование, имевшее прямой или косвенный контакт с Марсом, на Землю уже не вернется. Образцы грунта, перед тем как попасть на борт корабля, будут упакованы в специальный контейнер, а на Земле будут изучаться с соблюдением мер предосторожности, которые сегодня применяются при работе с вирусом Эбола. Пока же лабораторий, оборудованных в соответствии с этими требованиями, по словам представителей НАСА, не существует, и неизвестно, когда они будут созданы.
Бортинженер Дональд Петтит (6-я экспедиция МКС)
собирает пробы воды на анализ (водонагреватель в модуле «Звезда»)
собирает пробы воды на анализ (водонагреватель в модуле «Звезда»)
И здесь ученые сталкиваются с парадоксом. С одной стороны, даже недостижимые сегодня меры предосторожности стопроцентной гарантии защиты Земли от инопланетного вируса-убийцы не дают — ведь мы просто не знаем, с чем придется иметь дело. С другой стороны, если мы не можем привезти на Землю ничего живого, то, соответственно, мы не в состоянии это живое изучать. Система, таким образом, одновременно страдает неполнотой и избыточностью.
Прямое загрязнение
С прямым загрязнением тоже все непросто. Хотя в основу этой части Договора о космосе положено благородное стремление не навредить иным мирам, ученых больше волнует другой аспект заражения чужой биоты земными микробами. Они опасаются связанных с таким загрязнением сложностей с поиском марсианских микроорганизмов или хотя бы химических следов их метаболизма. Земная бактерия вряд ли устроит бойню обитателям Красной планеты, но, проникнув в грунт, она может мутировать, приспосабливаясь к новым условиям жизни, и когда ее найдут, ее могут не узнать и принять за местную жительницу.
[media=https://youtu.be/oJL2f8SpWhU]
Процедура, которая должна предотвратить прямое загрязнение, сводится к стерилизации. В НАСА перед стартом прогревают все детали корабля до 110 градусов (выше точки кипения воды), что уничтожает большинство микроорганизмов. Те детали, которые прогревать нельзя, моют спиртом. Наши специалисты, готовясь к так и не состоявшемуся полету на Марс в 1994 году, все узлы корабля (кроме электроники) подвергали гамма-излучению. Но ни эта мера, ни дополнительная «стерилизация» при проходе корабля через плотные слои атмосферы не могут уничтожить всех микробов на его поверхности. Считается, что корабль можно сажать на планету, если на квадратном метре его поверхности после обработки осталось не больше 500 спор. И что? Значит, дезинфекция не работает?
Если на Марсе появятся колонисты, то каждый их выход на поверхность тоже будет сопровождаться стерилизацией, процедура которой будет похожа на ту, которая применяется при работе с уже упомянутым вирусом Эбола. Это существенно удорожает и без того недешевую миссию будущего и весьма усложнит работу исследователей.
Надо полагать, что в отличие от обратного загрязнения, защита от которого будет всегда, защита от прямого загрязнения может стать временной мерой, приемлемой лишь на стадии изучения Марса. Но поскольку иные планеты человечество будет не только изучать, но и заселять, на этой стадии колонистам будет уже не до сантиментов об убиваемой микрожизни. Сегодня кажется сказкой идея о заселении других планетных систем, поскольку сегодня мы и добраться-то до них не способны, а заселение Марса представляется нам далекой и несбыточной научной фантастикой. Но серьезные ученые уже сейчас строят рассчитанные на долгие века планы по превращению Красной планеты во вторую Землю. И тогда, возможно, от защиты чужой жизни люди перейдут к нападению на нее.
Про Землю в общем то понятно, но вот про Марс есть другое мнение.
Защищать Марс от заражения земными микробами и тратить большие средства на тщательную стерилизацию марсианских автоматических зондов не имеет смысла — земные микроорганизмы попали на Красную планету еще миллиарды лет назад с метеоритами, пишут американские астробиологи в статье, опубликованной в журнале Nature Geoscience.
С начала космической эры ученые предпринимают жесточайшие меры для защиты инопланетных «экосистем» от потенциального заражения земными микроорганизмами. Эта практика закреплена договором 1966 года о принципах деятельности государств по исследованию и использованию космического пространства — он предписывает избегать вредного загрязнения Луны и других небесных тел. Меры по межпланетной «антисептике» вырабатывает международный Комитет по космическим исследованиям (КОСПАР).
Особенно строгие требования предъявляются к посадочным зондам, отправляющимся на Марс — на этой планете, как полагают ученые, может существовать микробная жизнь, и ее столкновение с земными «гостями» может привести к непредсказуемым последствиями. Кроме того, как считается, появление земных микробов может сделать бессмысленными попытки обнаружить «исконно марсианскую» жизнь.
Однако астробиологи Альберто Фэйрен (Alberto Fairen) из Корнеллского университета и Дирк Шульце-Макуч (Dirk Schulze-Makuch) считают, что эти предосторожности не имеют смысла уже несколько миллиардов лет.
«Мы полагаем, что земная жизнь, вероятнее всего, уже была перенесена на Марс. Жизнь существует на Земле, по меньшей мере, 3,8 миллиарда лет, так что было достаточно времени, чтобы процесс переноса произошел естественным образом — путем ударов метеоритов… Кроме того, в прошлом частота падений метеоритов была выше, чем сегодня», — пишут ученые.
Они отмечают, что на данный момент можно считать доказанным возможность переноса микроорганизмов с «попутными» метеоритами. Процесс межпланетного переноса начинается с удара крупного космического тела по обитаемой планете — этот удар может вышибать в космос достаточно крупные обломки породы, внутри которых могут оказаться микроорганизмы.
Затем эти обломки могут упасть на Марс — как на Землю попадают марсианские и лунные метеориты. Шансы на выживание «пассажиров» повышаются благодаря сравнительно тонкой марсианской атмосфере, в которой метеориты при падении нагреваются слабее, чем в земной.
Фэйрен и Шульце-Макуч допускают, что земные микроорганизмы, попавшие на Марс миллиарды лет назад, когда условия на этой планете были значительно благоприятнее, могли исчезнуть к настоящему моменту. В этом случае не имеет смысла беспокоиться о заражении из-за космических зондов. Если же жизнь на Марсе возникла независимо от земной, она еще миллиарды лет назад столкнулась с земными «гостями». Марсианские микроорганизмы, если они еще есть, не увидят ничего неожиданного, встретив микробов, привезенных автоматическими станциями.
Можно сэкономить
Ученые полагают, что с очень большой долей уверенности можно считать Марс уже «завоеванным» земными микробами. «Следовательно, уже слишком поздно защищать Марс… и мы можем ничего не опасаясь ослабить меры планетарной защиты», — говорится в статье.
Ее авторы полагают, что меры по стерилизации потребуются только в тех случаях, когда автоматические зонды будут исследовать ту среду, где марсианская жизнь может существовать сейчас — и то, только затем, чтобы не перепутать микроорганизмы-аборигены и привезенные с собой.
«Поскольку сейчас межпланетные исследования во всем мире столкнулись с серьезными сокращениями бюджета, критически важно избегать ненужных расходов и перенаправить деньги налогоплательщиков на миссии, которые могут внести наиболее существенный вклад в планетные исследования», — пишут ученые.
Они полагают, что меры по защите от потенциального заражения можно отменить для орбитальных зондов и серьезно пересмотреть для марсоходов и посадочных аппаратов.